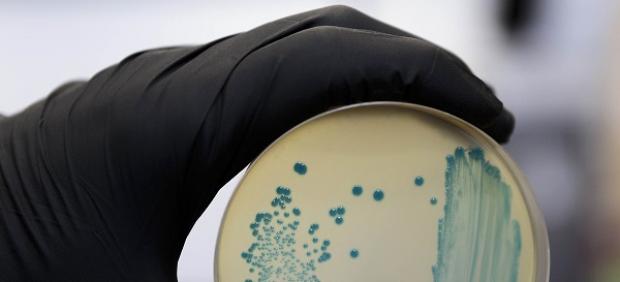
Listeria monocytogenes

ARACELI GUEDE
- En el Día Mundial de la Sepsis, en la que puede desembocar la listeriosis, la doctora disecciona estas afecciones.
- "Una vez que pase creo que vamos a aprender mucho de este brote", apunta.
- Nueva alerta sanitaria por listeria tras el consumo de Chicharrón Especial de La Montanera del Sur.
España se encuentra inmersa en la mayor crisis de listeria que ha sufrido, una de las peores registradas incluso a nivel mundial. Más de 200 afectados, tres muertos y siete abortos son hasta el momento las cifras de un brote que saltó a los medios el pasado 15 de agosto, cuando la Junta de Andalucía decretó la alerta sanitaria sobre carne de la marca La Mechá, elaborada por la empresa sevillana Magrudis.
Coincidiendo con el Día Mundial de la Sepsis, patología en la que puede desembocar la listeriosis, la doctora Eleonora Bunsow explica en qué consisten estas afecciones. Nacida en Argentina, se licenció en Medicina en la Universidad de Buenos Aires. Completó su residencia en microbiología clínica y enfermedades infecciosas en el Hospital Gregorio Marañón de Madrid y su tesina se títula Infección por listeria, un problema emergente en la salud pública. Actualmente es directora médica de la empresa bioMérieux Iberia.
¿Dónde se encuentra la listeria?
Puede estar en cualquier lugar. A veces la encontramos donde no pensábamos que se podía dar, pero es una bacteria que está generalmente en el suelo y puede asentarse en distintos alimentos. Es la forma en la que ingresa en nuestro organismo.
¿Cómo afecta al cuerpo?
Puede causar una infección a nivel digestivo, a veces con síntomas pseudo gripales. En otros casos, generalmente en personas con el sistema inmune comprometido, la infección puede extenderse, atravesar el tubo digestivo y provocar una bacteriemia, que significa que la bacteria entra en sangre. Suelen ser niños menores de dos años, adultos mayores de 65 o pacientes con cáncer, diabetes o alguna enfermedad crónica.
Las embarazadas también son vulnerables.
La placenta es un tejido por el que tiene predilección. Lo más peligroso es que afecte al feto. Puede provocar que el niño nazca con secuelas. La listeria se puede diseminar en su organismo, producir abscesos o microabscesos por los órganos y generar una enfermedad que generalmente lleva a la muerte. El feto puede morir incluso antes de nacer o haber un parto prematuro.
¿Qué especificidades presenta?
Es una bacteria bastante especial, tiene tropismos, predilección por algunos sitios, y otro de ellos es el sistema nervioso central. Por eso hay pacientes que no solo presentan grastroenteritis, bacteriemia o sepsis, sino también una meningitis.
Además es resistente.
Sí. Es bastante fuerte frente al frío. No se va congelando la carne. Con un tratamiento con mucho calor sí debería morir. Pero si en esa cadena algo falla, sobrevive.
¿Se contagia?
No.
Utensilios en contacto con un producto contaminado sí pueden dar problemas.
Eso es distinto. Está en el suelo y puede contaminar cualquier fase del proceso de realización de un producto. También puede llegar a las frutas y las verduras por ejemplo. Por eso hay que lavarlas bien. Y no solo por la listeria.
¿Cuál es su incidencia habitual?
No es frecuente que se den brotes como el de ahora. Pero siempre tenemos casos esporádicos que van goteando y generalmente están relacionados con alimentos que no sido bien procesados. Lo que ha ocurrido pone de manifiesto la importancia del control de los alimentos.
¿Qué ha podido pasar esta vez?
Se está investigando. Se presume cuál es la fuente. Si hay mucha cantidad de producto que ha sido consumido por mucha gente se propaga. La cantidad del inóculo ha sido alta en todos los productos. Y lamentablemente entre los pacientes los había muy susceptibles.

Su tesina apuntaba a "un problema emergente en la salud pública" y es de 2010. ¿Se veía venir?
A través de ese estudio que realizamos en el Hospital Gregorio Marañón vimos la evolución durante un periodo. Comparando los tiempos observamos que en la segunda mitad del periodo investigado había más casos de listeria y sobre todo entre mayores. Pero era una situación de casos esporádicos. En un brote la población afectada va a ser de cualquier edad.
¿A qué se debía ese aumento?
A que tenemos una población cada vez más envejecida y cada vez somos más invasivos, por ejemplo en las cirugías, que dejan a los pacientes más débiles. También tenemos más cánceres y más tratamientos agresivos contra ellos que debilitan el sistema inmune. Una de las razones por las que vemos mucho más estas enfermedades en los adultos es porque esta población está creciendo.
Y somos más vulnerables a las bacterias por el abuso de antibióticos.
Ese es un tema muy importante. La OMS puso la resistencia antimicrobiana en el Top 10 de problemas más graves en el mundo. También es verdad que se está dando una evolución tecnológica que ayuda al diagnóstico. Antes había enfermedades que desconocíamos porque no las detectábamos.
¿Deja secuelas?
Cuando una bacteria ingresa en el organismo y produce una bacteriemia, una sepsis o una meningoencefalitis... Cada lóbulo y cada hemisferio es distinto pero puede dejar secuelas neurológicas graves, sobre todo en los recién nacidos. Puede hacer microabscesos en hígado, vasos, sistema nervioso central… lesiones que pueden ser irrecuperables.
¿Qué tratamiento se sigue para la listeriosis?
Un tratamiento antibiótico que es bastante efectivo. Dependiendo de la afectación va a ser de un tipo y durante un periodo concreto. Algunas embarazadas requieren más tiempo. Los neonatos también. Y si hay afectación del sistema nervioso central buscaremos unos antibióticos que atraviesen mejor la barrera encefálica. Hay algunos pacientes que no necesitan tratamiento, que tienen un cuadro de diarrea y ni consultan al médico. Otros sí lo requieren para sobrevivir.
¿Esta ha sido una de las peores crisis en esta materia?
En España seguro y en el mundo es una de las más graves. Es sorprendente el número de afectados. Es algo que nunca esperábamos. Pero una vez que pase creo que vamos a aprender mucho de este brote. Tenemos que ver el perfil del paciente, cómo fue afectado, si fue más agresiva que otras listerias, si esta cepa era distinta… Me gustaría saber bien cuántas meningitis hubo, cuántas embarazadas infectadas… Tendríamos que analizarlo para ver si podemos tomar medidas para evitarlo.

Habla de la sepsis como una de las patologías en las que puede derivar la listeriosis. ¿Qué es?
Es la respuesta inflamatoria del organismo de forma desmedida frente a una infección por una bacteria, virus, parásito u hongo. Esa respuesta lesiona los órganos y tejidos, produciendo un fallo multiorgánico que puede llevar a la muerte si no se diagnostica y trata a tiempo.
¿Cuál es su incidencia?
En el mundo hay entre 37 y 40 millones de pacientes al año, con nueve millones de muertes. En España son 50.000 y 17.000 de ellos fallecen. El impacto económico además es muy alto. Son pacientes que necesitan ingreso, tiempo de hospitalización, no trabajan durante ese periodo… Se estima que los costes por cada caso en España son de 17.000 euros aproximadamente. En EE UU ascienden hasta los 50.000 dólares.
¿Qué síntomas presenta?
Muy diversos porque tiene mucho que ver con el sistema inmune y la genética del paciente. Algunas señales son fiebre, escalofríos, piel pálida o moteada, olvidos, desorientación o disminución de la orina.
¿Qué tratamiento se aplica?
Tenemos dos brazos muy importantes. En la era de la resistencia antimicrobial, primero es muy importante conocer el perfil del microorganismo y su resistencia. Hay que poner tratamiento antibiótico o antimicrobiano y tener en cuenta que hay casos en los que se debe drenar el sitio de infección para que el antibiótico penetre. Por otro lado tenemos el sistema inmune del paciente. Hay que darle sostén, con fluidos, con oxígeno, vasopresores… manteniendo su estado hemodinámico para que el cuerpo sea a su vez capaz de combatir la infección.
¿Hacia dónde va la investigación?
Se trabaja en saber cómo afectan el sistema inmune y la genética y en big data o modelos matemáticos para poder identificarla de forma más rápida por parte del médico.
¿Dónde se pone el foco en el día mundial?
En concienciar. Es una enfermedad con grandes efectos en la población pero es la gran desconocida. Hay que decirle a la gente que existe pero que hay formas de prevenirla y una es la vacunación. Igualmente es importante que la población esté informada y tome el antibiótico cuando se le dice y no lo haga cuando no debe. Hacer un buen uso repercutirá en nuestros hijos. No van a tener antibióticos si seguimos así.

![Lenovo -LEGION- Savior Y480 [$47.73] - FRESH IN](https://static.shareasale.com/image/18925/02528C6007A114FCA3181020DB029F8E.jpg)

No hay comentarios:
Publicar un comentario